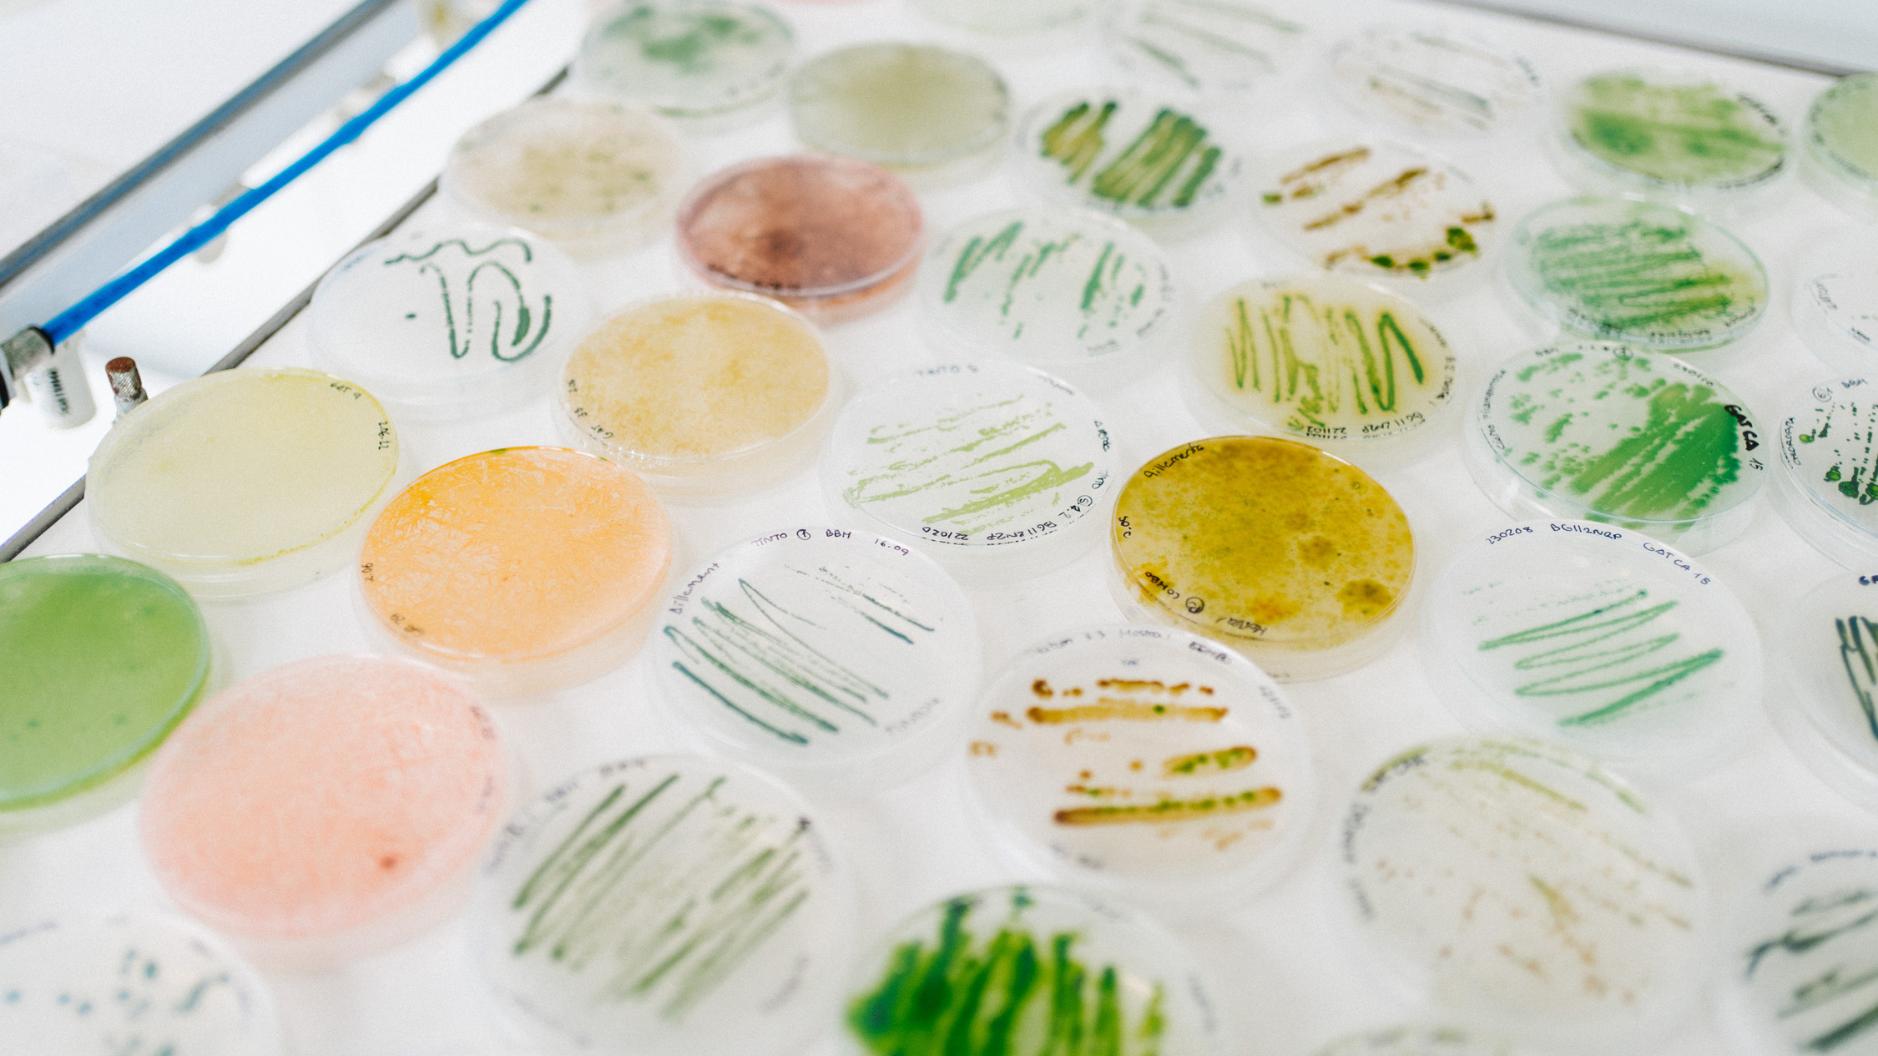

Nos actifs nouvelle génération
Le soin capillaire propulsé par les dernières avancées biotech.

Intégrer aujourd'hui les actifs de demain : plus durables, plus concentrés et plus performants.
Les microalgues
Le futur d'une cosmétique plus efficiente
Dotées de propriétés nutritives exceptionnelles, les microalgues enrichissent nos formules pour offrir des soins capillaires hautement efficaces.
Grâce à leur culture durable, sans empiéter sur les terres agricoles, et leur capacité à capter le CO2, les microalgues incarnent une avancée écologique majeure en cosmétique.
La révolution qui suractive nos soins
Grâce à des techniques innovantes basées sur la science des lipides, la fermentation améliore la composition et la concentration en actifs de nos huiles. Leurs vertus nutritives et leur biodisponibilité sont décuplées pour une efficacité accrue.
Peu énergivore et générant peu de déchets, la fermentation révolutionne la cosmétique moderne.
Les huiles fermentées

nos actifs phare en action
Biome Scalp Care
Des bioactifs à l’efficacité démontrée véhiculés par des eaux botaniques de qualité supérieure : notre signature pour des soins capillaires avant-gardistes.
Des actifs cliniquement prouvés, des résultats visibles
Nos bioactifs garantissent des résultats exceptionnels pour la santé de votre cuir chevelu et la beauté de vos cheveux.
Voyez la différence par vous-même.
Découvrez leurs performances cliniques.
Des eaux botaniques de qualité supérieure
Une quête d'excellence et des meilleurs producteurs.
Nous collaborons avec une entreprise familiale située dans le sud de la France qui produit et distille des plantes depuis plus de cinq générations.
Leur savoir-faire artisanal, transmis de génération en génération, offre des eaux biologiques d'une qualité inégalée.
"Mon cuir chevelu n'a jamais été aussi confortable et je perds beaucoup moins de cheveux"
Jessica L.

Notre promesse
Le rituel capillaire réinventé